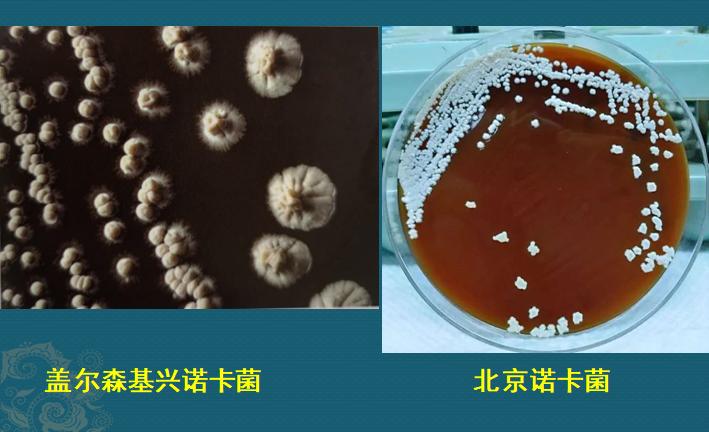
肺诺卡菌感染，当1种分解落叶的细菌，被吸入肺脏

问大家个问题:落叶归根,树叶是怎么变成泥土的?是谁把落叶分解成土壤肥料的?
别急,听豪大夫娓娓道来,这涉及到一种少见但严重的肺炎,也提示了戴口罩的益处。
地球表面经过亿万年的演化,已经形成完美的生物循环:动物的尸首,会由化脓菌和霉菌来分解,其中铜绿假单胞菌主要负责分解油脂和低分子蛋白。而凋零的植物,落叶归根,枯叶化土,就交给了诺卡菌来降解。

上面右图是一小片飘满落叶的土壤表面,干枯的落叶被诺卡菌逐步分解变成泥土,哪些白色小棒状结构,就是就是在草茎上繁殖出来的诺卡菌菌落,凑近了闻一下,有泥土的味道,跟我们在实验室里培养出来菌落味道一样。
其中最常见的一种叫星形诺卡菌,是的,因为它在培养基里长出来的菌落像一个个小星星:

所以,植物凋零,尘归尘、土归土,是因为地球表面有诺卡菌的勤恳工作,它们广泛存在于空气、土壤、海水、淡水、腐烂的植被及动物的排泄物中。
而当它们不小心被人类吸入肺脏,在一些免疫力下降的人群中,就有可能引发诺卡菌肺炎。
所以大家就明白了,它的好发季节是干燥、温暖的季节,这个季节可以在空气中出现大量含有诺卡菌微粒的气溶胶,经呼吸道吸入感染。
所以春暖花开,空气中弥漫泥土的芬芳,免疫力低下的人春游一定要戴口罩!

诺卡菌是个什么菌?
这是一种需氧型革兰阳性杆菌,隶属于放线菌目、棒杆菌亚目、诺卡菌科,因为含有气生菌丝,曾经误把它当作一种真菌。它的营养要求不高,在多种培养基上均能生长。一般在25~45℃均能生长,生长速度缓慢,培养24~48小时才能长出非常细小的菌落,初代分离常需要孵育一周,有时甚至需要4~6周。
把它们的菌落涂抹到玻璃片上,放到显微镜下观察,大致是下图右边这个样子,像一些凌乱的碎线头,有些诺卡菌有分枝:

诺卡菌的另一个特点是涂片时难以将该菌挑起和移动,因为诺卡菌的营养菌丝与培养基结合紧密,这点其实也好理解,它分解落叶时也是如此,菌丝深入叶脉,让枯叶直接崩解,化作土壤的肥料。
研究细菌时,科学家会给各种细菌用化学试剂涂上颜色,但这种细菌的细胞壁有大量含有分枝菌酸的脂质,不易着色,但通过加热及延长染色时间可以着色,并且不易被酸性脱色剂退色,称为抗酸染色阳性,这一点有时跟结核杆菌不太好区分,需要用改良的弱抗酸染色方法来鉴别,不要当成肺结核去治疗,无效。
另外,在诺卡菌感染的组织中,常可见“硫磺样颗粒”,这是诺卡菌聚集形成的微粒(如下图),取这种颗粒做涂片,镜检阳性率高。
诺卡菌肺炎是怎么发生的?
诺卡菌属于条件致病菌,不是人体正常菌群,一般不呈内源性感染,故健康人少见,免疫缺陷的人多见。而免疫缺陷,包括全身缺陷和肺部免疫功能下降,全身免疫缺陷包括艾滋病、应用激素、器官移植、恶性肿瘤化疗等等情况;肺部免疫下降包括吸烟、支气管扩张、慢阻肺等。
各类慢性消耗者常常出现低蛋白血症,所以当肺部出现不明原因肺炎,同时伴有低蛋白血症,尤其是常规抗生素治疗无效时,要高度警惕诺卡菌感染。
需要重点说明的是,眼部感染在非全身免疫缺陷的人群中更常见,致盲、致死率高。
上面我们提到,有学者发现,诺卡菌在干燥、温暖的气候条件下更容易流行,因为干燥、多风的条件下,更利于机体吸入含有诺卡菌的气溶胶。大约50-70%的病人是呼吸道吸入含有细菌或者断裂菌丝片段的气溶胶被感染,其次是伤口感染,如开放性骨折、开放性胸外科手术、隆胸术后感染等,少部分患者可以通过院内感染。

诺卡菌是一种选择性细胞内微生物,进入人体后生长在巨噬细胞和组织中,通过产生索状因子和诱导溶酶体酶活性,降低巨噬细胞中吞噬体和溶酶体的融合,从而防止被杀死。通过全基因组测序分析,发现诺卡菌的一些毒性基因,包括碱性磷酸酶、酪蛋白水解肽酶、溶细胞素、溶血酶、脂肪酶、金属蛋白酶、磷酸酶和磷脂酶等,共同引起肺部感染、脑脓肿、皮肤感染、肝脓肿、心瓣膜炎等疾病。
诺卡菌肺炎的CT表现
按照地球的微生物进化分工,诺卡菌原本是降解落叶的,不小心飘入人类的肺脏里(条件致病菌),想降解人体组织,会受到人体免疫细胞的制约和灭杀,呈现不同的发展速度和肺部表现,表现为急、慢性化脓性肺炎,缺乏特征性。
常见的CT表现为:
早期常表现为支气管壁增厚、小叶中心结节、树芽征和支气管扩张样改变,还常常合并非结核分枝杆菌感染。炎症继续发展,会出现下面CT表现:
1.局限或弥漫的肺部磨玻璃影、斑片影、但大部分表现为肺实变;
2.单个或多个结节、团块状影,结节大小不等,早期可以呈多发粟粒状;
3.空洞常见,因为诺卡菌引起的是化脓性感染,病变肺组织坏死后随痰液排出,会形成空洞。
下面4位病人,都是病原学确诊的诺卡菌肺炎,病情进展后几乎都会形成空洞:

部分病例来自网络
诺卡菌空洞有一个显著特点是:几乎看不到液平面。就是说,空洞里常常没有液态的脓液,是崩解的坏死肺组织、含有菌丝的细菌、炎症细胞、少许液化坏死组织等共同组成的碎渣状物,甚至有种土腥气(泥土味的诺卡菌混合坏死组织),是个重要提示。
诺卡菌肺炎的治疗
诺卡菌对磺胺类、氨基糖苷类、部分头孢菌素类、碳青霉烯类和喹诺酮类药物敏感,一般首选磺胺类药,但近年来发现磺胺类药耐药率较高,多主张联合用药,参照药敏试验。利奈唑胺几乎对所有的诺卡菌敏感,多用于重症感染、播散性诺卡菌感染及对磺胺药过敏者,有潜力成为首选药物。
该病治疗周期较长!对免疫功能正常者的肺诺卡菌病,治疗3个月;对免疫抑制的病人,至少需治疗6个月;有中枢神经系统播散的病人,应延长到12个月;对艾滋病继发感染的病人,需要12个月甚至更长时间。对免疫抑制的病人,建议低剂量维持治疗。
如果出现脓胸、心包积液、抗菌治疗无效的脑脓肿等,通常需要手术治疗。

我是影像科豪大夫,分享小病例,传递正能量,欢迎关注!
#湖南医聊超能团# #健康科普排位赛#